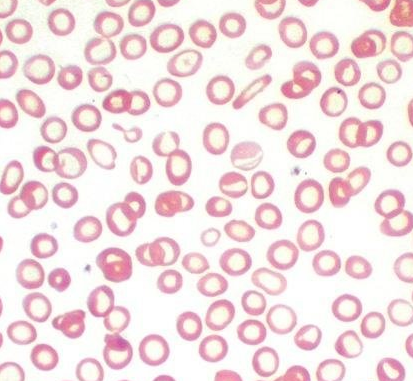
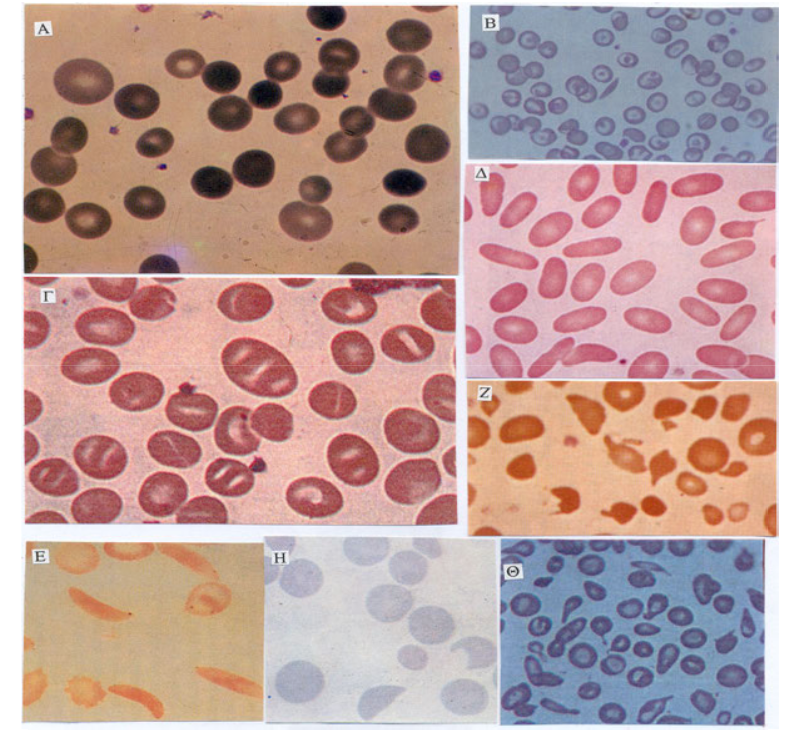
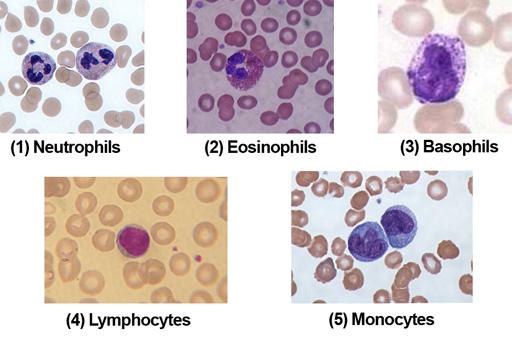
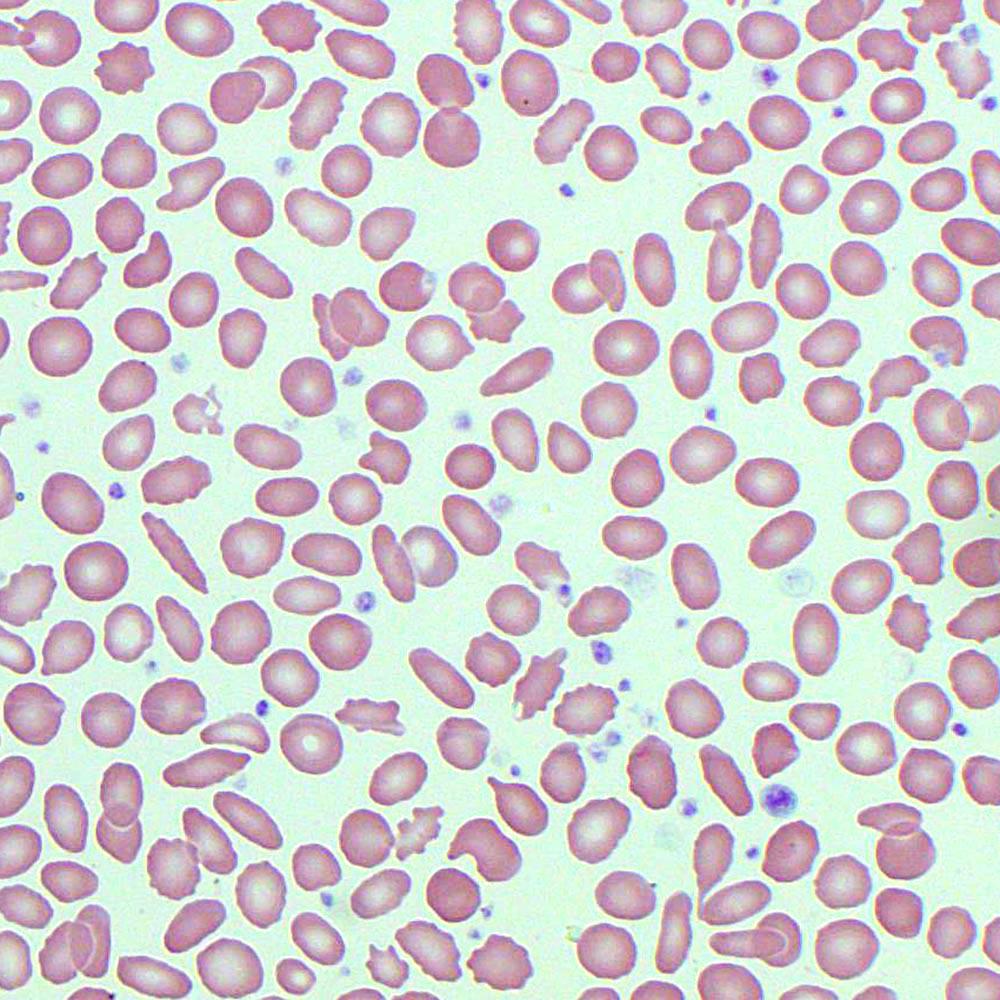

Ερμηνευτική προσέγγιση στη γενική εξέταση αίματος
![]() 14-4-2021
14-4-2021
![]() Χριστίνα Καπέτση
Χριστίνα Καπέτση

Κάθε άνθρωπος, ανεξαιρέτως, σε κάποια περίοδο της ζωής του έχει χρειαστεί να κάνει μια γενική εξέταση αίματος. Σε πολλούς από αυτούς, η γενική αίματος λαμβάνει χώρα ως μέρος ενός προληπτικού ελέγχου, ενώ σε άλλους μπορεί να αποτελεί έκτακτη ή και επείγουσα εξέταση, για τον εντοπισμό, την ταυτοποίηση αλλά και την εξέλιξη κάποιας πάθησης. Η σπουδαιότητα αυτής της εξέτασης είναι πολύ μεγάλη και για αυτό το λόγο θεωρείται από πολλούς επιστήμονες ως καθρέφτης της υγείας μας. Σκοπός του συγκεκριμένου άρθρου είναι να αποκτήσουμε μια πιο ολοκληρωμένη εικόνα όσον αφορά το αίμα, αλλά και κάποιες βασικές παραμέτρους που συναντάμε σε μια γενική εξέταση αίματος, και τί πληροφορίες μας δίνουν για την υγεία μας. Όλα αυτά, σαφώς και δεν αποσκοπούν στη γνωμάτευση της υγείας μας από εμάς τους ίδιους, άλλωστε αυτό αποτελεί αποκλειστικό καθήκον του θεράποντα ιατρού μας. Κύριος στόχος είναι ο περιορισμός της ανησυχίας και του φόβου στη θέα μιας αυξημένης ή αντίστοιχα χαμηλής τιμής, καθώς επίσης η βαθύτερη και πιο σφαιρική γνώση του οργανισμού και της υγείας μας.
Αξιζεί να αναφερθεί οτι στο εν λόγω άρθρο δεν αναγράφονται φυσιολογικές τιμές για τις εξετάσεις που απαρτίζουν τη γενική αίματος. Παρά το γεγονός οτι οι φυσιολογικές τιμές κάθε εξέτασης είναι συγκεκριμένες, μπορεί να παρατηρήσουμε κάποιες μικρό διαφορές απο εργαστηρίο σε εργαστήριο οι οποίες σχετίζονται με τα μηχανήματα και τα αντιδραστήρια που χρησιμοποιεί το εκάστοτε διαγνωστικό κέντρο.
ΤΙ ΕΙΝΑΙ ΤΟ ΑΙΜΑ
Το αίμα αποτελεί ένα εξειδικευμένο και άκρως σημαντικό σωματικό υγρό. Αποτελείται από άμορφα και έμμορφα συστατικά. Στα άμορφα συστατικά συγκαταλέγονται οι οργανικές (λιπίδια, ένζυμα, ορμόνες κ.α.) και οι ανόργανες ουσίες (νερό, ηλεκτρολύτες κ.α.) ενώ στα έμμορφα συστατικά περιλαμβάνονται τα ερυθρά αιμοσφαίρια ή ερυθροκύτταρα, τα λευκά αιμοσφαίρια ή λευκοκύτταρα και τα αιμοπετάλια ή θρομβοκύτταρα.
Οι ποικίλες λειτουργίες του αίματος είναι αυτές που το καθιστούν ένα ζωτικής σημασίας υγρό του σώματος. Μεταξύ αυτών, σημαντικότερες λειτουργίες είναι:
- Η μεταφορά οξυγόνου και θρεπτικών ουσιών από τους πνεύμονες στους ιστούς
- Ο σχηματισμός θρόμβου με σκοπό την παρεμπόδιση μικρής ή μεγάλης απώλειας αίματος σε περίπτωση τραυματισμού
- Η μεταφορά κυττάρων και αντισωμάτων στοχεύοντας στη καταπολέμηση μιας μόλυνσης
- Ο καθαρισμός και το φιλτράρισμα του αίματος από μη ωφέλιμες ουσίες με τη μεταφορά τους στους νεφρούς και το συκώτι
- Και τέλος, η ρύθμιση της θερμοκρασίας του σώματος
ΤΙ ΕΙΝΑΙ Η ΓΕΝΙΚΗ ΕΞΕΤΑΣΗ ΑΙΜΑΤΟΣ;
Ως γενική εξέταση αίματος χαρακτηρίζεται η ποσοτική και αδρή μορφολογική μελέτη των έμμορφων συστατικών του αίματος. Η μελέτη δηλαδή των λευκών αιμοσφαιρίων, των ερυθρών αιμοσφαιρίων και των αιμοπεταλίων.

ΕΡΥΘΡΑ ΑΙΜΟΣΦΑΙΡΙΑ (Red Blood Cells -RBC)
Τα ερυθρά αιμοσφαίρια παράγονται στο μυελό των οστών και καταλαμβάνουν το μεγαλύτερο πληθυσμό των έμμορφων στοιχείων του αίματος. Η κύρια βιολογική τους αποστολή είναι η μεταφορά οξυγόνου από τους πνεύμονες στους ιστούς και η επιστροφή του διοξειδίου του άνθρακα από τους ιστούς στους πνεύμονες με τη βοήθεια της αιμοσφαιρίνης. Ένας αυξημένος αριθμός ερυθρών αιμοσφαιρίων μπορεί να είναι ένδειξη μιας ασθένειας ή διαταραχής, αν και δεν υποδηλώνει πάντα κάποιο πρόβλημα υγείας.
Μερικές περιπτώσεις στις οποίες μπορεί να σημειωθεί αύξηση ερυθρών αιμοσφαιρίων είναι:
- Συγγενής καρδιοπάθεια
- Αφυδάτωση
- Υποξία ( χαμηλά επίπεδα οξυγόνου στο αίμα )
- Νεφρική νόσος
- Κάπνισμα κ.α
Ενώ αντίθετα, η μείωση ερυθροκυττάρων ενδέχεται να σχετίζεται με κάποια μορφή αναιμίας.
ΑΙΜΟΣΦΑΙΡΙΝΗ (Hemoglobin – HGB ή HB)
Η αιμοσφαιρίνη είναι μια χρωμοπρωτείνη, αποτελείται δηλαδή από μια χρωστική, την αίμη, η οποία είναι υπεύθυνη για το κόκκινο χρώμα του αίματος και μια πρωτεϊνη τη σφαιρίνη. Αποτελεί το σημαντικότερο κατά βάρος συστατικό των ερυθρών αιμοσφαιρίων, ενώ συγχρόνως είναι ο κύριος φορέα της λειτουργικότητας τους. Η περιεκτικότητα της αιμοσφαιρίνης διαφέρει σε κάθε κύτταρο και αποτελεί σημαντικό δείκτη για τη διαφορική διάγνωση των ποκίλων τύπων αναιμίας. Σοβαρά εγκάυματα, χρόνια αποφρακτική πνευμονοπάθεια (ΧΑΠ), διαβίωση σε μεγάλο υψώμετρο αλλά και η λήψη ορισμένων φαρμάκων αποτελούν μερικές περιπτώσεις αύξησης της αιμοσφαρίνης. Αντίθετα, περιπτώσεις υπερβιταμίνωσης Α, σιδηροπενικής αναιμίας, εγκυμοσύνης, λευχαιμίας και άλλες συνοδεύονται απο πτώση της τιμής της αιμοσφαιρίνης.

Φυσιολογικά ερυθρά αιμοσφαίρια σε μικροσκοπική εξέταση
Ερυθρά αιμοσφαίρια απο άτομο με σιδηροπενική αναιμία
ΑΙΜΑΤΟΚΡΙΤΗΣ (Hematocrit – HCT ή HT )
Ως αιματοκρίτης ορίζεται η ποσότητα των ερυθρών αιμοσφαίριων στο συνολικό όγκο του αίματος. Η μέτρηση αυτής της αναλογίας χρησιμεύει στη διάγνωση καθώς επίσης και στη παρακολούση μιας θεραπείας.
Ένας χαμηλός αιματοκρίτης μπορεί να υποδηλώνει:
- Ανεπαρκή ποσότητα υγιών ερυθρών αιμοσφαιρίων ( αναιμία )
- Ανεπάρκεια βιταμινών
- Υπερυδάτωση
- Πρόσφατη ή μακροχρόνια απώλεια αίματος κ.α
Ένας αυξημένος αιματοκρίτης μπορεί να οφείλεται σε:
- Αφυδάτωση
- Πολυκυτταραιμία ( διαταραχή κατα την οποία το σώμα μας παράγει πάρα πολλά ερυθροκύτταρα )
- Πνευμονικές ή καρδιακές παθήσεις
- Νεφρικές διαταραχές κ.α
Επιπλέον, εκτός απο τα προαναθερθέντα, στη γενική αίματος περιλαμβάνονται και άλλοι δείκτες, οι οποίοι είναι οι εξής:
- Μέσος όγκος ερυθρών (MCV)
- Μέση περιεκτικότητα αιμοσφαιρίνης (MCH)
- Μέση συγκέντρωση αιμοσφαιρίνης (MCHC)
- Εύρος κατανομής ερυθρών (RDW–CV)
Οι δείκτες αυτοί βοηθούν στη διαφορική διάγνωση των αναιμιών και δηλώνουν το μέγεθος και την περικετικότητα της αιμοσφαιρίνης των ερυθροκυττάρων.
ΜΟΡΦΟΛΟΓΙΑ ΕΡΥΘΡΩΝ
Τέλος, στη μορφολογία των ερυθρών αναγράφονται ερυθρά αιμοσφαίρια τα οποία έχουν αλλοιωμένη φυσιολογική μορφολογία ως προς το σχήμα και το μέγεθος τους και για αυτό το λόγο ανευρίσκονται και σε πολλές παθολογικές καταστάσεις. Μερικά κύτταρα αυτού του είδους είναι τα ακόλουθα:
- Δρεπανοκύτταρα
- Δακρυοκύτταρα
- Σχιστοκύτταρα
- Στοχοκύτταρα
- Ακανθοκύτταρα κ.α
Ερυθροκύτταρα με αλλοιωμένη φυσιολογική μορφολογία: Α) Σφαιροκύτταρα Β) Στοχοκύτταρα Γ) Στοματοκύτταρα Δ) Ελλειπτοκύτταρα Ε)Δρεπανοκύτταρα Ζ) Σχιστοκύτταρα Η) Κρανοκύτταρα Θ) Δακρυοκύτταρα
ΛΕΥΚΑ ΑΙΜΟΣΦΑΙΡΙΑ (WHITE BLOOD CELLS – WBC)
Τα λευκά αιμοσφαίρια παράγονται στον μυελό των οστών, βρίσκονται στο αίμα και τους λεμφαδένες και αποτελούν μόλις το 1% του συνολικού αίματος. Αν και βρίσκονται σε μικρό ποσοστό έχουν τεράστια σημασία για τον ανθρώπινο οργανισμό. Τα κύτταρα αυτά είναι υπεύθυνα για τη προστασία και την άμυνα του οργανισμού έναντι ξένων εισβολέων που ενδέχεται να προκαλέσουν κάποια λοίμωξη ή και ασθένεια στον άνθρωπο. Οι διακυμάνσεις των λευκών αιμοσφαιρίων οφείλονται συνήθως σε διαταραχές μιας υποομάδας τους,των ουδετεροφίλων.
Τα λευκά αιμοσφαίρια διακρίνονται σε 5 υποομάδες:
- Τα Ουδετερόφιλα
Τα κύτταρα αυτά σκοτώνουν βακτήρια και μύκητες, αποτελούν τον πιο πολυάριθμο τύπο λευκών αιμοσφαιρίων και λειτουργούν ως πρώτη γραμμή άμυνας σε περίπτωση κάποιας λοίμωξης.
Αιτίες ουδετεροφιλίας ( αύξηση δηλαδή των ουδετεροφίλων ) αποτελούν:
- Οι λοιμώξεις απο βακτήρια και μύκητες
- Οι μεταβολικές διαταραχές
- Νεοπλαματικά νοσήματα του αίματος κ.α.
Αιτίες ουδετεροπενίας ( ελάττωση δηλαδή των ουδετεροφίλων ) αποτελούν:
- Ιογενείς λοιμώξεις
- Αυτοάνοσα νοσήματα κ.α.
- Τα Λεμφοκύτταρα
Αυτά τα κύτταρα δημιουργούν αντισώματα με σκοπό τη καταπολέμηση βακτηρίων, ιών και άλλων δυνητικά επιβλαβών εισβολέων. Η συνηθέστερη αιτία παθολογικής λεμφοκυτταρώσεως ( αύξηση λεμφοκυττάρων ) είναι οι οξείες ιογενείς λοιμώξεις ενώ φυσιολογική λεμφοκυττάρωση συμβαίνει στα παιδία μέχρι την ηλικία των 4 ετών.
- Τα Μονοκύτταρα
Αυτού του είδους τα λευκά κύτταρα έχουν μεγαλύτερη διάρκεια ζωής απο πολλά λευκά αιμοσφαίρια και βοηθούν στη διάσπαση των βακτηρίων. Αύξηση των μονοκυττάρων παρατηρείται σε λοιμώξεις, φλεγμονώδη νοσήματα και νεοπλασίες του αίματος.
- Τα Ηωσινόφιλα
Τα ηωσινόφιλα συμμετέχουν στην άμυνα ένατι των παρασίτων και των καρκινικών κυττάρων όπως επίσης και σε αλλεργικές αντιδράσεις. Η αύξηση τους εντοπίζεται σε αλλεργικές καταστάσεις, δερματοπάθειες, νεοπλασίες κ.α.
- Τα Βασεόφιλα
Η εμφάνιση αυτών των μικρών κυττάρων κρούει το κώδωνα του κινδύνου όταν μολυσματικοί παράγοντες εισβάλουν στο αίμα και βοηθούν στον έλεγχο της ανοσολογικής απόκρισης. Μια απο τις περιπτώσεις βασεοφιλίας ( αύξηση βασεόφιλων ) αποτελεί η χρόνια μυελογενής λευχαιμία.
Μορφολογία λευκών αιμοσφαιρίων σε μικροσκοπική εξέταση
ΑΙΜΟΠΕΤΑΛΙΑ (PLATELETS – PLT )
Τα αιμοπετάλια είναι πολύ μικρά κύτταρα του αίματος που παράγονται και αυτά στο μυελό των οστών, έχοντας διάρκεια ζωής 8 – 10 ημέρες και έπειτα απομακρύντονται απο τη κυκλοφορία του αίματος απο το σπλήνα. Κύριο χαρακτηριστικό των αιμοπεταλίων αποτελεί η δυνατότητα τους να δημιουργούν θρόμβους αίματος για να επιβραδύνουν ή να σταματήσουν την αιμορραγία και να βοηθήσουν στην επουλώση της πληγής. Όταν για παράδειγμα υποστούμε κάποιο τραυματισμό ο οποίος δημιουργεί ανοιχτή πληγή και κατ’ επέκταση απώλεια αίματος, τα αιμοπετάλια αναγνωρίζουν το τραυματισμένο αγγείο και φθάνοντας στο σημείο εκείνο δημιουργούν μεγάλα κολλώδη πλοκάμια για να επιτύχουν το σχηματισμό θρόμβου.
Η μορφή των αιμοπεταλίων κάτω απο το μικροσκόπιο
Η αύξηση αιμοπεταλίων ονομάζεται θρομβοκύττωση και μπορεί να προκύψει σε:
- Οξεία Αιμορραγία
- Μετεγχειρητικά
- Φλεγμονή κ.α
Αντίθετα η κατάσταση όπου παρατηρείται μείωση των αιμοπεταλίων ονομάζεται θρομβοπενία και ανευρίσκεται σε :
- Αναιμία
- Αιμορραγία
- Αυτοάνοσες διαταραχές κ.α
Τέλος, εκτός απο το ποσοστό των αιμοπεταλίων σε μια γενικη εξεταση αίματος αναφέρονται και άλλοι δείκτες οι οποίοι είναι χρήσιμοι για τη διερεύνηση αιμορραγικών διαταραχών. Οι δείκτες αυτοί είναι οι ακόλουθοι:
- Αιμοπεταλιοκρίτης ( PCT )
- Μέσος όγκος αιμοπεταλίων ( MPV )
- Εύρος κατανομής αιμοπεταλίων ( PDW )

Η απεικόνιση των κυττάρων του αίματος μέσα απο ηλεκτρονικό μικροσκόπιο
Τέλος, τα αριθμητικά αποτελέσματα απο μια γενική εξέταση αίματος μπορεί να απεικονίζονται και με τη μορφή διαγραμμάτων, τα οποία βοηθούν τους θεράποντες στη καλύτερη κατανόηση και αξιολόγηση των αποτελεσμάτων.

Ας εντάξουμε λοιπόν τη γενική αίματος στα πλαίσια ενός προληπτικού ελέγχου που είναι καλό να κάνουμε όλοι μας ανά τακτά χρονικά διαστήματα και να μην το αμελούμε. Είναι χρήσιμο να ενημερωνόμαστε σωστά για θέματα που αφορούν την υγεία μας. Κατ’ αυτό το τρόπο, αποκτούμε μια πιο ολοκληρωμένη εικόνα και μπορούμε ευκολότερα να κατανοήσουμε τι συμβαίνει στον οργανισμό μας και πως όλα τελικά είναι αλληλένδετα μεταξύ τους!
ΕΛΛΗΝΙΚΗ ΒΙΒΛΙΟΓΡΑΦΙΑ
- Διαγνωστική Αθηνών, Μικροβιολογικό και Ερευνητικό Εργαστήριο
- Σεραφειμίδου Ο. & Παντζιαρέλα Ε. , 2008, Εργαστηριακή Προσέγγιση Στη Γενική Αίματος, Εκδόσεις Α. ΑΛΤΙΝΤΖΗ
- Βαγδατλή Ε. ,2014, Έμμορφα Στοιχεία Του Αίματος, Μετρήσεις Και Σφάλματα Στον Αιματολογικό Αναλυτή, Εκδόσεις Α. ΑΛΤΙΝΤΖΗ
ΞΕΝΗ ΒΙΒΛΙΟΓΡΑΦΙΑ
- Genesis Specialist Hospital ( https://genesishospitalng.com/ )
- American Society Of Hematology (https://www.hematology.org/ )
- National Institute Of Allergy And Infectious Diseases ( https://www.ncbi.nlm.nih.gov/ )
- Britannica ( https://www.britannica.com/ )
- U.S. National Library Of Medicine ( https://medlineplus.gov/ )
- Cleveland Clinic ( https://my.clevelandclinic.org/ )
- University Of Rochester, Medical Center ( https://www.urmc.rochester.edu/ )
- Mayo Clinic ( https://www.mayoclinic.org/ )
- Cambridge Dictionary ( https://dictionary.cambridge.org/ )
- National Cancer Institute ( https://www.cancer.gov/ )
- Johns Hopkins Medicine ( https://www.hopkinsmedicine.org/ )
- Pathology Student ( https://www.pathologystudent.com/ )
- Research Gate ( https://www.researchgate.net/ )
- Harvard Health Publishing, Harvard Medical School (https://www.health.harvard.edu/ )
- Open Learn ( https://www.open.edu/openlearn/ )
TrueMed-ForLivingMore
Κοινοποιήστε



Αρχές Βιοηθικής και Διαχείρισης των Ζώων στην Βιοϊατρική Έρευνα και την Κτηνιατρική Επιστήμη
Η παρούσα μελέτη, προσεγγίζοντας το ζήτημα των καινοτόμων θεραπευτικών σχημάτων επιχειρεί να αναδείξει το ευρύτερο πλαίσιο και τις αρχές στο πεδίο της βιοηθικής και διαχείρισης των ζώων στην βιοϊατρική έρευνα και την κτηνιατρική επιστήμη

Βήμα προς βήμα το θερμικό σοκ σε ένα βρέφος
Το θερμικό σοκ σε βρέφη είναι ταχύτατα εξελισσόμενο και δυνητικά θανατηφόρο.
Κάθε λεπτό καθυστέρησης αυξάνει τον κίνδυνο βλάβης ή θανάτου.
ΡΟΗ ΕΙΔΗΣΕΩΝ
ΔΙΑΒΑΣΤΕ ΕΠΙΣΗΣ
Βρείτε μας στο Facebook και στο Instagram
Επικοινωνία
Η ομάδα μας
Διαφημιστείτε στη truemed.gr
Όροι χρήσης
Προσωπικά δεδομένα
Copyright©Truemed
Για περισσότερη ζωή
Designed – Developed by Premiumweb.gr
| Επικοινωνία | Η ομάδα μας | Διαφημιστείτε στη truemed.gr| | Όροι χρήσης | Προσωπικά δεδομένα | Copyright©Truemed | |Για περισσότερη ζωή |
Designed – Developed by Premiumweb.gr

© 2019 TrueMed Media. All rights reserved. Our website services, content, and products are for informational purposes only. TrueMed Media does not provide medical advice, diagnosis, or treatment.
Αρθρογράφος
Η Χριστίνα Καπέτση γεννήθηκε στις 20 Ιουνίου του 1996 στη Θεσσαλονίκη, όπου και έζησε τα παιδικά - εφηβικά της χρόνια και εξακολουθεί να αποτελεί τη μόνιμη βάση της. Από τότε που θυμάται τον εαυτό της ως επαγγελματικό όνειρο είχε να μπει στην Αστυνομία ή το Στρατό. Η υγεία δεν ήταν ένας τομέας μέσα στον οποίο έβλεπε τον εαυτό της να εργάζεται και να εξελίσσεται. Παρόλα αυτά, το 2014 εισήχθη στο τμήμα Ιατρικών Εργαστηρίων του Αλεξάνδρειου Τεχνολογικού Εκπαιδευτικού Ιδρύματος Θεσσαλονίκης (Βιοιατρικές Επιστήμες – Διεθνές Πανεπιστήμιο Ελλάδος, σήμερα), απ΄ όπου και αποφοίτησε το 2019 με άριστα. Σήμερα, εργάζεται στο μικροβιολογικό τμήμα μιας Ιδιωτικής Κλινικής της Θεσσαλονίκης και θεωρεί το επάγγελμα της αναπόσπαστο κομμάτι του εαυτού της, μέσα από το οποίο μπορεί να εξελιχθεί και να προσφέρει όχι μόνο στη δουλεία της αλλά και στους αγαπημένους της ανθρώπους. Το 2021 δεν μπορεί να φανταστεί τον εαυτό της να κάνει κάτι διαφορετικό. Βασικό πλεονέκτημα του χαρακτήρα της αποτελεί η οργάνωση και η πλήρης αφοσίωση σε αυτό που κάνει, γεγονός που τη μετατρέπει σε τελειομανή και αγχώδη άνθρωπο. Στον ελεύθερο της χρόνο απολαμβάνει να διαβάζει βιβλία, καθώς το θεωρεί μια άκρως αγχολυτική δραστηριότητα. Στόχος της είναι κάποια στιγμή να ζήσει και να εργαστεί στο εξωτερικό, σε μια πόλη όπου ευδοκιμεί το επάγγελμα της, να συμμετάσχει σε ερευνητικάprojectsκαι να γνωρίσει άλλα πρότυπα, μεθόδους και συνθήκες εργασίας. ΗTrueMedαποτελεί γι’ αυτήν στάδιο εξέλιξης. Συγκεκριμένα, η προσπάθεια για συλλογή έγκυρων πληροφοριών, η απόκτηση νέων γνώσεων και ως τελικό στάδιο η σύνταξη ενός προσωπικού άρθρου με σκοπό την ενημέρωση και ευαισθητοποίηση του κόσμου αποτελούν το έναυσμα για την εξέλιξη της και την αποφυγή της στασιμότητας!
Λοιπά Προσόντα
Ξένες Γλώσσες:Αγγλικά ( ΕπίπεδοC2 ), Ρουμάνικα ( Δεύτερη Μητρική Γλώσσα )
ΕιδικέςΓνώσεις: Πιστοποιητικό Πληροφορικής(Windows,Word,Excel,Access,Internet,PowerPoint )
Πιστοποιήσεις – Συνέδρια :
- Πρώτες Βοήθειες (BLS)
- Υγεία – Υπογονιμότητα και Περιβάλλον
- ΙατρικάTabooκαι Μύθοι
- Καρκίνος του Πνεύμονα – Από τη διάγνωση στη θεραπεία
- Ανακαλύπτοντας και Σ.Μ.Ν κ.α
Αριθμός άρθρων που έχει γράψει στην Truemed: 2









